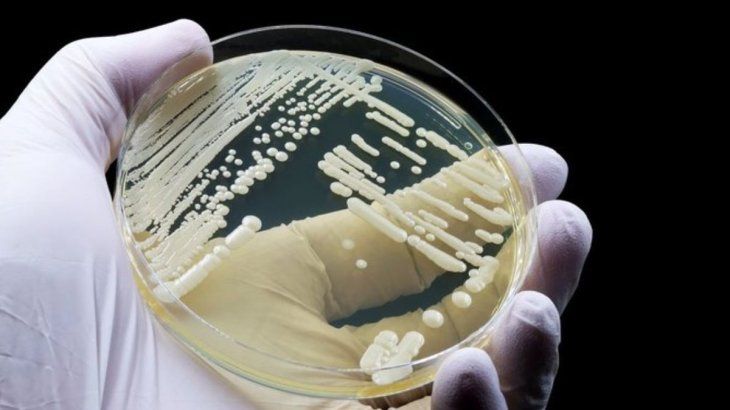

No se puede caminar por un bosque en una parte del noroeste de Estados Unidos, en el estado de Washington, sin tropezar con un hongo, una erupción del poco conocido reino Fungi, del que depende toda la vida y cuya importancia se discutirá en la COP16 de Colombia.
Aseguran que "los hongos están más cerca de ser animales, que plantas"
Según los especialistas, las setas no son plantas ya que se alimentan de algo más que su fotosíntesis. Su investigación puede beneficiar a muchos aspectos de la vida humana.
-
El asteroide que contiene componentes genéticos básicos para la vida
-
Qué es la teoría de la cebolla y cómo aplicarla en tu pareja para que dure más
Algunos son altos y delgados con la parte superior en forma de casco, otros son grandes florituras de pliegues parecidos a un cerebro. Muchos podrían parecer una delicia en manos de un chef experto, aunque otro tanto... definitivamente no. Pero las docenas de especies que investigadores y aficionados recogieron en una mañana reciente representan solo una pequeña fracción de estas formas de vida que no son ni vegetales o ni animales.
"Las setas no son plantas", zanjó Amy Honan, profesora de micología y ecología fúngica en la Universidad de Oregón. "Los hongos están más emparentados con los animales que con las plantas". Las especies vegetales fabrican su propio alimento por fotosíntesis, pero aquellas correspondientes al reino de los hongos tienen que comer algo más. "Escupen diferentes enzimas, por lo que descomponen su alimento fuera de su cuerpo, y lo sorben como un batido", explicó Honan.
Solo se conoce un 6% del total de especies de hongos
De las al menos 2,5 millones de especies de hongos que se cree que existen en la Tierra, los científicos han descrito unas 150.000, el 6%, aseguró Honan a la AFP durante una excursión cerca de Port Angeles, estado de Washington. Comparado con lo que se sabe de las plantas y los animales, esto es prácticamente nada. "Conocemos el 98% de los vertebrados del planeta", precisó la experta. "Conocemos alrededor del 85% de las plantas que existen, y conocemos alrededor del 20% de los invertebrados". Esta escasez de conocimientos sobre los hongos es preocupante por el papel vital -y en gran medida oculto- que desempeñan.
Estas formas de vida evolucionaron antes que las plantas y crearon las condiciones para que la vegetación pasara del mar a la tierra. "Los hongos son esenciales para todos los ecosistemas terrestres. Confieren todo tipo de beneficios a las plantas, desde tolerancia a la sal, tolerancia a los metales pesados, resistencia a las enfermedades", añadió Honan "Básicamente, sin hongos... las plantas no existirían. Necesitamos las plantas para el oxígeno, así que el mundo no existiría en su estado actual", completó.
También estaría repleto de cosas muertas. "Los hongos descomponen toda la materia orgánica muerta, por lo que reciclan todo ese carbono y otros nutrientes" facilitando el ciclo vital de plantas y animales, señaló Honan.
Cada vez hay más conciencia de la importancia de los hongos, cuyo papel se debatirá en la cumbre COP16 del Convenio sobre la Diversidad Biológica de la ONU, que comienza este lunes en la ciudad de Cali, en el suroeste de Colombia. El periódico británico The Guardian informó la semana pasada que una propuesta conjunta de Chile y Reino Unido podría suponer el reconocimiento de los hongos como "un reino de vida independiente en la legislación, las políticas y los acuerdos, con el fin de avanzar en su conservación y adoptar medidas concretas que permitan mantener sus beneficios para los ecosistemas y las personas".
Los hongos benefician la vida humana
Una mayor protección sería una buena noticia, aseguró el micólogo Graham Steinruck, que, junto a Honan, dirige un estudio sobre la biodiversidad fúngica en un lugar que estuvo sumergido hasta la retirada de una presa hace unos años. Como parte del Festival Olympic Peninsula Fungi, él y Honan han llevado a los participantes al campo para enseñarles a encontrar especies de hongos y a registrar lo que ven. "Creo que cuantos más hongos descubramos y documentemos no solo nos informarán sobre nuestra biodiversidad, sino también sobre cómo podemos gestionar mejor la tierra", sostuvo Steinruck.
Saber más sobre estos misteriosos organismos también puede beneficiar a muchos aspectos de la vida humana. Las setas pueden ayudarnos a "curarnos a nosotros mismos, e incluso potencialmente (ayudar) a otras cosas como las industrias", afirmó.
Para los participantes en la cacería de hongos, la oportunidad de encontrar nueva vida fúngica fue reveladora. Naomi Ruelle había viajado desde Nueva York con su pareja aficionada a las setas, y participó en su primera búsqueda organizada. "He aprendido mucho", dijo sonriendo, mientras mostraba una colección que incluye un enorme espécimen carnoso, hongos amarillos tipo sombrilla y otros con tallos enroscados que han echado raíces en un cono de pino muerto. "Ha sido muy interesante ver las distintas especies. Obviamente se las van a llevar al laboratorio y tengo curiosidad por saber un poco más sobre ellas", aseguró.

Dejá tu comentario